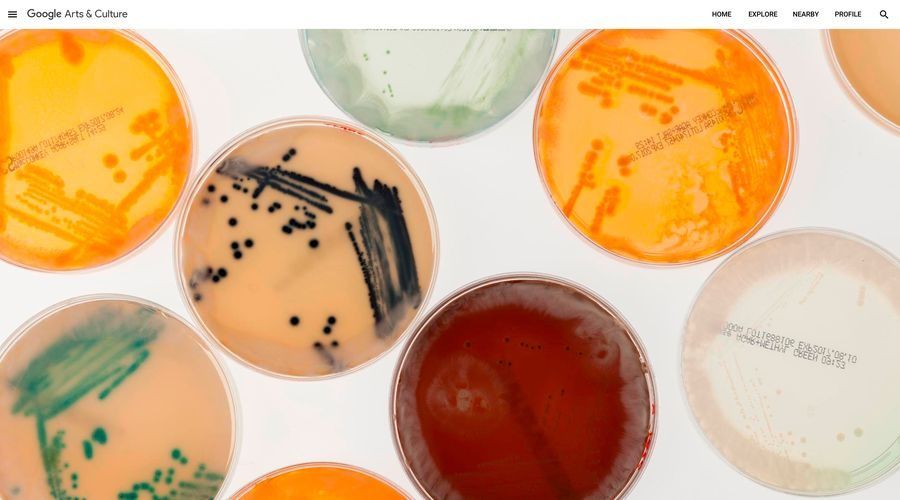

Once Upon a Try, a maior exposição on-line sobre invenções e descobertas já criadas, está agora disponível no Google Arts and Culture. Graças a mais de 110 instituições parceiras e curadores e arquivistas de 23 países em várias partes do mundo é possível hoje explorar o progresso humano em Once Upon a Try – com 350 exposições interactivas.
Leia o post de, Liudmila Kobyakova, Program Manager Google Arts & Culture:
Das primeiras ferramentas de pedra aos braços robóticos, da máquina a vapor à propulsão a jacto, à internet – as novas tecnologias alimentaram a fantasia e moldaram a sociedade humana. Basta olhar para o exemplo do telescópio. Hoje, o Telescópio Espacial Hubble orbita 340 milhas acima da órbita da Terra, capturando imagens nítidas de 10.000 galáxias, algumas das quais com 13 mil milhões de anos. A ideia do telescópio nasceu em 1608, como uma ideia do criador de óculos holandês Hans Lippershey, e que, posteriormente, Galileu Galileu melhorou o design e apontou-o para o céu.
Hoje estamos a celebrar estes objetos quotidianos, sonhados e criados por inventores, cientistas e sonhadores. Graças a mais de 110 instituições parceiras e curadores e arquivistas de 23 países em várias partes do mundo é possível, hoje, explorar o progresso humano em Once Upon a Try – com 350 exposições interactivas. A maior exposição on-line sobre invenções e descobertas já criadas, está agora disponível no Google Arts and Culture.

Explore CERN’s 27 km long Large Hadron Collider with Street View 
See a collection of 100 digitised notes from Albert Einstein Explore the incredible work of scientists leading the fight against superbugs Dr Kathryn D Sullivan, NASA astronaut who launched the Hubble Space Telescope into orbit Marie Curie in her laboratory The first heart-bypass was performed by René Favaloro in Argentina
Enquanto parte da exposição Once Upon a Try, é também possível aceder a uma aplicação de realidade aumentada “Big Bang” do CERN, desenvolvida em colaboração com o Google Arts & Culture que permite ao utilizador embarcar numa jornada épica de 360 graus através do nascimento e da evolução do universo. Com Tilda Swinton como guia, testemunhe a formação das primeiras estrelas e observe o planeta Terra a ganhar forma na palma da sua mão.
Com recurso ao machine learning da Google, os utilizadores poderão também explorar o vasto arquivo da NASA de 127.000 imagens históricas com uma nova ferramenta chamada Universo visual da NASA. Veja a história das descobertas e das missões e pesquise por termos para conhecer mais sobre a agência espacial. Ou visite o space shuttle discovery – no Smithsonian National Air Space Museum – em 360 graus e com os astronautas que, um dia, fizeram dela a sua casa.
Mergulhe no Street View para visitar os locais de grandes descobertas: do subterrâneo e profundo CERN até ao espaço, a bordo da ISS. Faça Zoom a 200.000 artefactos em alta resolução, como o primeiro mapa das Américas, e a Saturno e às suas 62 luas. Conheça as grandes invenções – dos emoji à casa de banho – ou ouça cinco cientistas inspiradores que falam sobre a ciência por detrás trás dos poderes dos super-heróis. E conheça os Einsteins e Curies, bem como uma série de heróis menos conhecidos, como Chewang Norphel, o homem que sozinho está a combater as mudanças climáticas com frigoríficos artificiais ou a paleontóloga feminina pioneira que descobriu o pterodáctilo.
Navegue por entre as exposições recheadas de histórias com acidentes frutuosos, falhas épicas e até mesmo pessoas que morreram pelos seus projectos – como a descoberta de raios X por Röntgen, o engenhoso submarino eléctrico de Isaac Peral que nunca foi lançado e como a busca de Marie Curie pelo polônio levou à sua própria morte por envenenamento radioactivo.
Apesar destes contratempos, o esforço humano é uma viagem sem fim, com apenas algumas coisas tão estimulantes como o momento “eureka” em que tudo começa a encaixar na perfeição. Conheça as dicas de que precisa para se tornar um inventor e saiba porque é importante aceitar o fracasso através das histórias de pioneiros como Ada Lovelace, Mae Jemison e Chien-Shiung Wu.
Esperamos que este tributo à descobertas da humanidade inspire uma nova geração de criadores para serem curiosos, procurarem o que está para além do conhecido e tentarem algo novo.
Explore o “Once Upon a Try” no Google Arts & Culture ou através da app para iOS e Android e junte-se à conversa em #onceuponatry.
Leia mais artigos sobre Arte e Cultura

Comentários